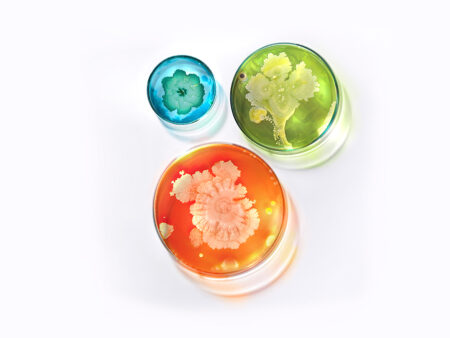

An organic yet powerful approach to managing acne
We have already discussed how our approach addresses the microbial imbalance created by our industrial lifestyles, so let’s take a closer look at the ingredients used in the Esse Clarifying Range and how…